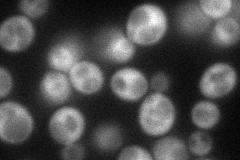
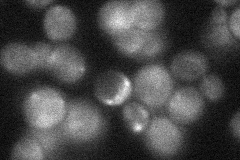

View description
DNA dependent ATPase/DNA helicase belonging to the Dna2p- and Nam7p-like family of helicases that is involved in modulating translation termination; interacts with the translation termination factors, localized to polysomes
Localization:
Intensity:
Fold change:
Significance:
-
C’ GFP library in SD

below threshold17.37 -
N' NOP1pr-GFP in SD
cytosol74.6828 -
N' TEF2pr-mCherry in SD

cytosol190.339 -
N' NATIVEpr-GFP in SD
cytosol30.9401 -
N' TEF2pr-VC and Cyto-VN in SD

below threshold50.4201 -
C’ GFP library in SD+DTT

cytosol15.280.87No -
C’ GFP library in SD+H2O2

cytosol18.551.06No -
C’ GFP library in Starvation Media

cytosol15.40.88No -
C’ GFP library on the background of Pup2-DaMP

below threshold -
C’ GFP library on the background of CCT mutant

below threshold17.90291.03026No
